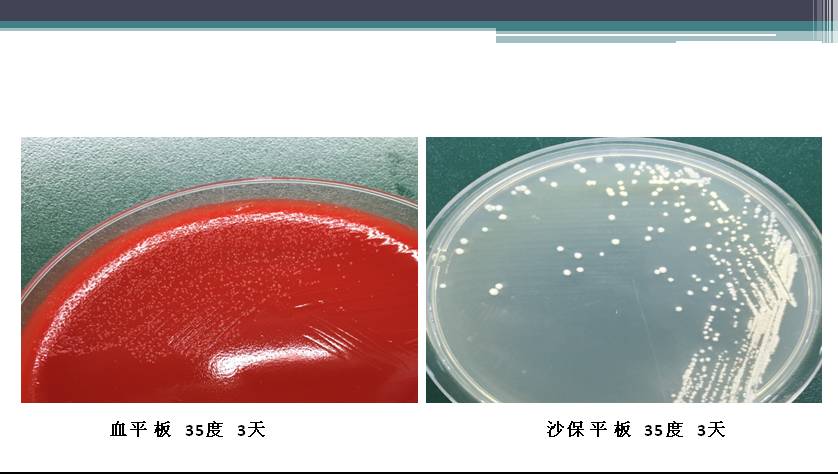

2018PIDMIC >一例胸壁脓肿患者病因分析
一例胸壁脓肿患者病因分析

陈栎江 温州医科大学附属第一医院
温州医科大学附属第一医院医学检验中心微生物组组长、科教学秘书。
从事临床微生物学检验、教学及研究工作,在病原菌的分离与鉴定、病原菌耐药监测有较深入的研究。
先后在国内外专业期刊上以第一作者发表学术论文多篇;参与浙江省自然科学基金和温州市科技局等多项课题。